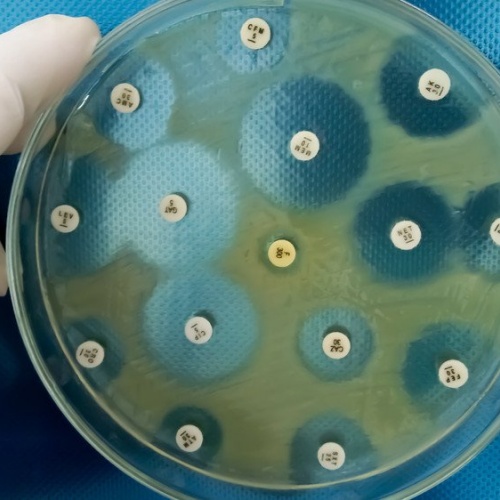

根据德国 AOK 科学研究所(WIdO)的数据,2023 年提交给法定健康保险(GKV)的抗生素处方数量明显增加:全年开具超过 3600 万盒,总费用超过 7.92 亿欧元。这一水平首次超过了 2019 年疫情前的水平。WIdO 警告称,全球每年约有 130 万人因抗生素耐药而死亡,其中德国约 9700 例。
抗生素处方趋势
2020 年和 2021 年抗生素处方数量有所下降,
2022 年开始回升,
2023 年更是同比增长超过 18%,显著高于疫情前水平,
自 2014 年起,抗生素处方原本呈下降趋势,但 2022 年的上升打断了这一趋势。
WIdO 执行董事 Helmut Schröder 表示:“储备型抗生素(Reserveantibiotika)的处方再次上升令人担忧,因为这可能进一步加剧耐药风险,尤其在危及生命的疾病中,其后果可能非常严重。”
储备型抗生素使用情况
储备型抗生素作为可能的最后治疗选择,2023 年仍有约 1600 万处方。Schröder 进一步指出:“储备型抗生素是宝贵的应急治疗选择,但处方数量再次上升,显示出它们的谨慎使用仍未得到充分落实。”
总体使用情况与地区差异
WIdO 统计数据显示,2023 年抗生素总使用量为 3.237 亿日剂量(DDD),相当于每 1000 名 GKV 被保险人 486 处方。
其中,标准抗生素占 275 处方 / 1000 人,储备型抗生素占 211 处方 / 1000 人。
地区差异明显:
汉堡:328 处方 / 1000 人,较为节制,
萨尔州:539 处方 / 1000 人,明显高于全国平均水平。
储备型抗生素比例方面:
不来梅最低,约 33%,
梅克伦堡-前波美拉尼亚州最高,超过 53%。
Schröder 强调:“尽管上述数据未考虑地区人口年龄、性别结构及疾病负担,但这些地区间的巨大差异,应引起对地方处方习惯的反思。”
动物养殖中抗生素的使用
动物养殖中抗生素的使用长期存在争议,也加剧了耐药性问题。不过,在这一领域的使用量持续下降,这得益于 《动物药物法》 的修订,要求将抗生素使用控制在治疗必需的最低限度。此外,自 2023 年起,还对通过药房、兽医管理部门或高校向兽医提供的抗生素进行了记录。
新型抗生素研发不足
WIdO 指出,过去十年内,仅 367 种新上市药物中有 8 种为抗生素。为应对供应短缺,德国政府通过 药品供应短缺防控法(ALBVVG) 提供了财政激励,并由联邦教育与研究部(BMBF)提供最高 5 亿欧元 支持新抗生素研发。
Schröder 提醒:“这些激励措施是否能真正推动新型抗生素的开发,还有待观察。”